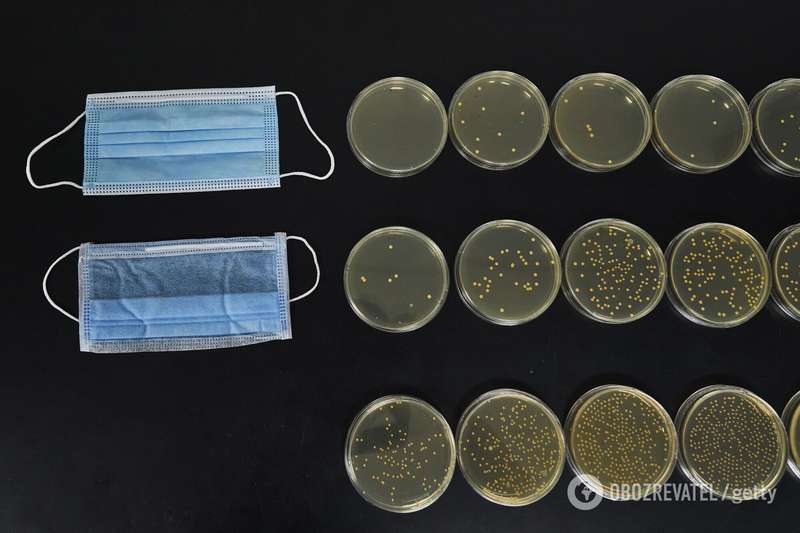
,         dqxikeidqxiqqeant

Доказана эффективность масок против COVID-19: пропускают в 10 тысяч раз меньше капель

Доказана эффективность масок против COVID-19: пропускают в 10 тысяч раз меньше капель
Человек, стоящий в двух метрах от зараженного коронавирусом без маски, подвергается воздействию в 10 тысяч раз большего количества капель этой инфекции.
К такому выводу в ходе исследования пришли ученые Эдинбургского университета Шотландии. Так, они еще раз доказали необходимость ношения средств индивидуальной защиты в период пандемии COVID-19, пишет Daily Mail.
По словам специалистов, капли вируса – крупные частицы, которые падают на землю и приземляются на поверхность, – являются основным двигателем передачи нового типа коронавируса.
Исследователи провели ряд экспериментов с реальными людьми, а также манекенами в натуральную величину, которые были подключены к машине, имитирующей кашель и речь. Позже они сравнили количество капель, упавших на поверхность перед человеком, кашляющим и говорящим в маске и без нее.
Результаты показали, что на человека, который стоит на расстоянии 2 м от того, кто кашляет и находится без маски, попадает в 10 000 раз больше капель, чем на того, кто стоит в полуметре и хотя бы в простой однослойной маске.
При этом, отмечают исследователи, якобы "ни одной капли" не пропустила специальная хирургическая маска. Поэтому ученые заверяют, что даже простая хлопковая маска "чрезвычайно эффективна".
"Мы знали, что маски для лица из различных материалов в разной степени эффективны при фильтрации мелких капель. Однако, когда мы специально посмотрели на те крупные капли, которые считаются наиболее опасными, то обнаружили, что даже простейшая маска ручной работы чрезвычайно эффективна. Следовательно, ношение масок действительно может иметь значение", – подчеркнула ведущий исследователь, доктор Игнацио Мария Виола.
Теги: маскиCOVID-19ЗаражениеВирусЭпидемия коронавирусакоронавирус

Коментарі:
comments powered by DisqusЗагрузка...
Наші опитування
Показати результати опитування
Показати всі опитування на сайті